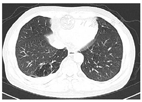
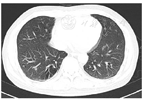

患者中年男性,长期吸烟,10月前于我科诊断为广泛期小细胞肺癌,经6周期EP化疗联合胸部同步放疗后肺部肿瘤病灶控制稳定,但半月前逐渐出现快步行走时气促。
快步行走时气促。肋间隙未见异常,双肺叩诊清音,双肺呼吸音稍粗,呼气相延长,未闻及干湿性啰音。
PET/CT提示肿瘤控制稳定,肺功能提示轻度混合性通气功能障碍,激发试验阳性,舒张试验阴性(舒张后FEV1/FVC 65.12%)。对比患者胸部CT,患者右下肺局限性肺气肿逐渐进展。考虑本次气促由慢性阻塞性肺疾病进展引起。
予沙美特罗氟替卡松吸入剂联合噻托溴铵粉吸入剂治疗后气促好转,出院后患者坚持长期使用三联药物。
患者肿瘤控制稳定,目前仍长期生存,生存时间已将近10年。针对慢性阻塞性肺疾病,患者在接受三联药物情况下,长期mMRC评分稳定在0分,生活质量良好,并且从未出现慢性阻塞性肺疾病急性加重。
呼吸与危重症医学科;肿瘤内科

版权归中华医学会所有。本文为遵循CC-BY-NC-ND协议的开放获取文章。
肺癌患者常合并慢性阻塞性肺疾病(以下简称慢性阻塞性肺疾病),但因为早期慢性阻塞性肺疾病症状的隐匿性以及肺癌和慢性阻塞性肺疾病所表现出的症状的相似性,在临床实践中我们往往忽视了对肺癌患者进行肺功能检查明确慢性阻塞性肺疾病诊断。我科在2012年收治了一位广泛期小细胞肺癌患者,该患者在肿瘤稳定控制后出现气促症状,经完善相关检查后最终考虑是由慢性阻塞性肺疾病进展引起的气促。患者之后长期规律使用三联吸入药物治疗慢性阻塞性肺疾病,在肿瘤控制稳定长期生存的情况下,未有气促症状及慢性阻塞性肺疾病急性加重。
患者因"确诊小细胞肺癌10月,气促半月"于2013年6月13日就诊我科。
现病史:患者男,55岁,10月前因面部及双上肢水肿至我科就诊。PET/CT(图1)示"1.纵隔型肺癌,肿瘤侵犯上腔静脉、升主动脉并压迫相邻气管;2.右中肺见1个结节影,考虑为右肺内转移灶;3.右肺门、右前纵隔、右侧锁骨上窝淋巴结多发转移;4.左侧肾上腺见低密度结节影,代谢未见增高"。头颅MRI未见转移。纤支镜右上肺叶活检组织及第2组、第4组淋巴结活检病理诊断为右上肺小细胞肺癌,纵隔淋巴结浸润。患者于2012年8月20日至2013年1月22日接受6周期EP化疗(顺铂40mg d1-3 +依托泊苷200mg d1-3)并行同步胸部放疗(60Gy/30F),患者无明显不适。2012年12月11日复查PET/CT仅见肿瘤少量残余,右中肺结节影病灶消失,达到部分缓解(PR)。后因出现新发颅脑转移,考虑肿瘤进展,2013年3月4日起更改化疗方案为"拓扑替康d1-5 2.5mg+奈达铂120mg d5"方案化疗2次。期间患者出现Ⅲ度骨髓抑制,于2013年5月3日、2013年5月27日行2次"拓扑替康2mg d1-d5"单药化疗,过程顺利。


半月前患者无明显诱因逐渐出现活动后气促,快步行走时明显,气促无昼夜关系,无咳嗽、咳痰及咯血,无胸闷、胸痛,无畏寒及发热,再次入住我科。
否认高血压、糖尿病、肺结核、肝炎,无过敏史。吸烟20年,平均40支/日,吸烟指数800支x年。父亲因结核去世。无家族遗传病史及家族肿瘤史。
体格检查:生命体征平稳。肋间隙未见异常,双肺叩诊清音,双肺呼吸音稍粗,呼气相延长,未闻及干湿性啰音。心脏听诊无异常。
2013年6月13日血气分析(21% FiO2):PH 7.4,PCO2 32mmHg,PO2 67mmHg,实际HCO3a 20.90mmol/L,SPO2 92%。
2013年4月28日胸部CT(与2013年3月27日对比) 1.右前上纵隔肿块及右肺门少许残留不规则软组织肿块,基本同前;2、双肺上叶及右肺下叶局限性肺气肿。
初步诊断:1.右肺广泛期小细胞肺癌放化疗后1)纵隔、右锁骨上窝淋巴结转移;2)右额叶转移;3)左侧肾上腺转移(?);2、肺气肿;3、低氧血症
患者本次因急性气促起病,主要考虑以下几种原因:1)针对肿瘤,患者2013.04 CT提示肿瘤原发病灶控制稳定,但考虑小细胞肺癌恶性程度高,易对化疗药物产生耐药并出现进展,因此本次出现活动后气促不排除小细胞肺癌进展所致。2)此外,患者长期吸烟,既往CT提示双上肺及右肺下叶肺气肿,符合慢性阻塞性肺疾病特点。本次气促不排除慢性阻塞性肺疾病进展所致。需进一步行肺功能检查明确慢性阻塞性肺疾病诊断。3)除上述2种病因,患者本次气促也需与放射性肺炎、肺栓塞相鉴别。
住院后给予低流量给氧,同时完善相关检验检查。血嗜酸性粒细胞计数0.14×109/L;D-二聚体正常。2013年6月14日PET/CT(图2): 1.纵隔内上腔静脉后组织稍增厚,代谢轻度增高,考虑为小细胞肺癌治疗后肿瘤处于明显抑制状态,与上次显像(2013年2月22日)相比病灶无明显变化;2.纵隔内多个淋巴结稍增大,代谢轻度增高,考虑为淋巴结转移灶经治疗后肿瘤处于抑制状态;3.双上肺及右下肺局限性肺气肿。肺功能提示轻度混合性通气功能障碍,舒张试验阴性,激发试验阳性(VC max 3.91L,占预计值76.4%;FVC 3. 86 L,占预计值75.3%;FEV1 2.48L,占预计值77.5%;舒张后FEV1/FVC 65.1%,舒张后FEV1 2.53L,占预计值79.1%)。同时对比患者2013年4月胸部CT(图3)与2012年10月胸部CT(图4),患者右下肺局限性肺气肿较前进展。患者无可变性气流受限症状,既往未有发作性气喘,双肺未闻及哮鸣音,不支持支气管哮喘诊断。综合以上检验检查结果,考虑患者本次气促与慢性阻塞性肺疾病进展相关。患者CAT评分>20分,激发试验阳性考虑存在气道炎症导致的气道高反应性,遂予沙美特罗氟替卡松吸入剂50μg/250μg(1吸,2/日)联合噻托溴铵粉吸入剂(1吸,1/日)治疗后患者气促症状好转后出院。






患者依从性良好,出院后继续规律吸入三联药物治疗慢性阻塞性肺疾病。2017年1月将吸入方案调整为布地奈德福莫特罗320μg:4.5μg(1吸,2/日)联合噻托溴铵粉吸入剂(1吸,1/日)治疗。患者坚持每年平均3个月返院复诊,mMRC评分长期稳定在0分,生活质量良好,且从未出现慢性阻塞性肺疾病急性加重。患者2016年11月4日复查肺功能提示FEV1 2.63L,占预计值80.8%,舒张试验阴性;2018年12月18日肺功能提示FEV1 2.52L,占预计值77.5%,舒张试验阴性;2021年8月10日肺功能提示FEV1 2.27L,占预计值69.8%,舒张试验阴性。患者平均每年FEV1减损70mL。虽然FEV1出现逐渐减损,但患者呼吸系统症状控制良好,无咳嗽及咳痰,无明显气促,近期mMRC评分0分,确诊慢性阻塞性肺疾病至今无急性加重。针对小细胞肺癌,患者之后出现小细胞肺癌病灶进展,之后予胸部及肾上腺放疗及细胞因子诱导的杀伤细胞(Cytokine-induced killer, CIK)治疗,患者肿瘤病灶控制良好,目前仍长期生存,未针对肿瘤行放化疗及免疫治疗,仅定期行影像学检查评估肿瘤控制情况。
回顾该患者长期诊疗经历,我们在治疗恶性肿瘤的同时也未忽视慢性阻塞性肺疾病的治疗。该患者在肺恶性肿瘤控制良好的情况下,通过规律吸入三联药物,获得了慢性阻塞性肺疾病的良好控制。患者长期无明显呼吸系统症状,且未发生过急性加重。
慢性阻塞性肺疾病是肺癌常见并发症,同时也是肺癌的独立危险因素[1]。研究显示肺癌患者合并慢性阻塞性肺疾病的比例在41%-50%[2,3],在男性患者中这一比例甚至高达72%[2]。因此当肺癌患者出现反复咳嗽、咳痰或气促症状时,需考虑患者是否合并慢性阻塞性肺疾病。在肺癌患者中早期识别患者是否合并慢性阻塞性肺疾病十分重要。但是在临床实践中,许多肺癌患者在首诊时并没有表现出典型的慢性阻塞性肺疾病症状,导致临床医生忽视了对慢性阻塞性肺疾病的诊断,特别是肺腺癌患者。一项研究提示肺腺癌患者通常合并轻度慢性阻塞性肺疾病,而肺鳞癌患者通常合并中至重度慢性阻塞性肺疾病[4]。这就要求临床医生在临床实践中提高对慢性阻塞性肺疾病的诊断意识和诊断能力。本病例患者首诊时以上腔静脉综合征为主要临床表现,当时并未表现出明显的慢性咳嗽、咳痰或者气促症状,因而我们最初忽视了对其慢性阻塞性肺疾病进行诊断。当肿瘤经过规律治疗控制稳定患者却出现气促症状时,我们方意识到患者可能合并慢性阻塞性肺疾病。此外,对慢性阻塞性肺疾病进行长期规律吸入药物治疗十分重要。长期规范的吸入药物治疗可以改善患者呼吸系统症状,延缓肺功能减损速度,减少急性加重次数,为患者手术治疗或者化疗及免疫治疗提供基础。在当今肿瘤治疗水平不断发展的背景下,许多肺癌患者获得了长期生存,若未对其中合并慢性阻塞性肺疾病的患者进行及时识别及规律治疗,那么即使患者获得了肿瘤稳定控制,一部分患者也可能因为肺功能的逐渐减损以及反复慢性阻塞性肺疾病急性加重而导致生活质量下降,甚至生存时间的减少。
因此,对肺癌患者及时进行肺功能检查并长期规律地针对慢性阻塞性肺疾病进行药物治疗具有十分重要的临床意义。此外,未来也需要更多的研究探讨慢性阻塞性肺疾病治疗对肺癌患者生存期的影响,以及肿瘤化疗、免疫治疗、胸部放疗等治疗方法对慢性阻塞性肺疾病患者症状、肺功能以及急性加重的影响。
所有作者均声明本研究不存在利益冲突